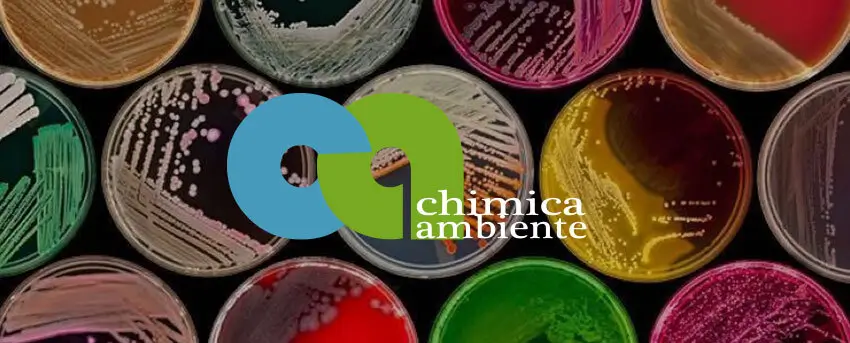

Anche quest’anno OMRON, azienda leader nell’automazione industriale, parteciperà a SPS Italia, la fiera di riferimento per l’industria intelligente, digitale e sostenibile. In un momento in cui la competitività europea, e …
Ultime notizie
Ultime Riviste
TECNO TV
In evidenza
-
-
Pochi temi stanno generando oggi una pressione maggiore sui laboratori analitici quanto i PFAS. UNICHIM presenta quattro cicli di prove interlaboratorio, con oltre 130 laboratori coinvolti nell’analisi di acqua potabile. …
-
NEWS
Stefania Ferrero, CMO di Comau, l’unica italiana selezionata tra le “IFR Women in Robotics 2026”
di redazione2Stefania Ferrero, Chief Marketing & Solutions Portfolio Officer di Comau, è stata selezionata tra le Top 11 Women Shaping the Future of Robotics 2026 dall’International Federation of Robotics (IFR), la …
-
CHIMICA
Battery storage: il mercato europeo dei BESS accelera e l’Italia si conferma tra i Paesi chiave per la crescita del settore
di redazione2Dopo 18 mesi di espansione, il settore europeo dello storage si trova ad affrontare sempre più spesso ostacoli normativi e di accesso alla rete. L’Europa è pronta a raddoppiare la …
-
FOOD
Atlas Copco Group Annual Report 2025: trasformare le sfide globali in opportunità locali
di redazione2La strategia di Atlas Copco Group per rispondere a un contesto macroeconomico caratterizzato da incertezza, tensioni geopolitiche, crescente protezionismo e mutamento delle priorità governative è chiara: concentrarsi su azioni con …
-
CHIMICA
Imprese: al via il Premio Impresa Sostenibile 2026 del Sole 24 Ore in collaborazione con Piccola Industria di Confindustria, candidature aperte fino al 23 settembre
di redazione2Prende il via la quinta edizione del Premio Impresa Sostenibile, l’iniziativa promossa dal Sole 24 Ore che valorizza le Piccole e Medie Imprese italiane capaci di coniugare crescita, innovazione e responsabilità. Un riconoscimento dedicato alle realtà che stanno …
-
EIT Food, tra le principali iniziative in Europa per l’innovazione alimentare, annuncia l’apertura ufficiale delle candidature per l’edizione 2026 di Empowering Women in Agrifood (EWA). Il programma, che mira a …
-
La Fondazione Acea nasce con la missione principale di tutelare e valorizzare il patrimonio storico, industriale e culturale dell’Azienda fondata a Roma nel 1909 dal sindaco Ernesto Nathan e dall’assessore …
-
FOOD
Interpack 2026, Aetna Group punta sull’end-of-line intelligente tra innovazione e mercati globali
di redazione2A Düsseldorf, negli spazi di Interpack 2026, Aetna Group sarà tra gli espositori principali con uno stand di circa 1.000 metri quadrati nel Padiglione 13 (stand A47), portando in fiera …
-
FOOD
Un solo nome, una visione globale: gli 8 marchi storici del gruppo diventano Crealis
di redazione2Dopo anni di integrazione a seguito di numerose acquisizioni Crealis apre un nuovo capitolo della sua storia ripensando la propria struttura globale con un obiettivo chiaro: rafforzare la competitività, accelerare …
-
Dopo oltre un secolo di storia imprenditoriale e cinquant’anni di innovazione nel settore dei macchinari per il confezionamento, Concetti S.p.A. annuncia una nuova fase nel proprio percorso di crescita, con …